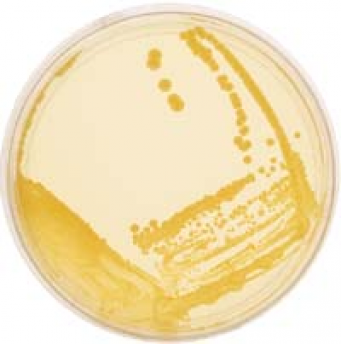

Bacterial Cultures (50 ml)
Products >> Consumables >> Microbiology >> Cultures >> Bacterial Cultures (50 ml)
Need More Information about Bacterial Cultures (50 ml)?
Question, comment or just feedback we want to know. Maybe you have question on what may compliment this product? We have the answers so ask the questions. We look forward to hearing from you.
Price: $69 + GST
Model Number: Various
Risk Group 1 (low risk) bacterial cultures are suitable for use in school PC1 laboratories. These strains represent a variety of morphologies, temperature sensitivities, antibiotic resistance and nutritional requirements (see downloadable pdf to the left):
BC-BS50, Bacillus subtilis
BC-BT50, Bacillus thuringiensis
BC-CF50, Citrobacter freundii
BC-EC50, Escherichia coli
BC-RR50, Rhodospirillum rubrum
BC-SL50, Sarcina lutea (Micrococcus lutea)
BC-SE50, Staphylococcus epidermidis (albus)
>> Cultures are shipped as 50 ml broths
Further information regarding 'Low Risk' organisms, PC1 and safety considerations can be found in the pdf to the left entitled Safety in Laboratories-Working Microbiologically. This document also outlines important information regarding laboratories where genetic manipulation (such as bacterial transformation) takes place.
